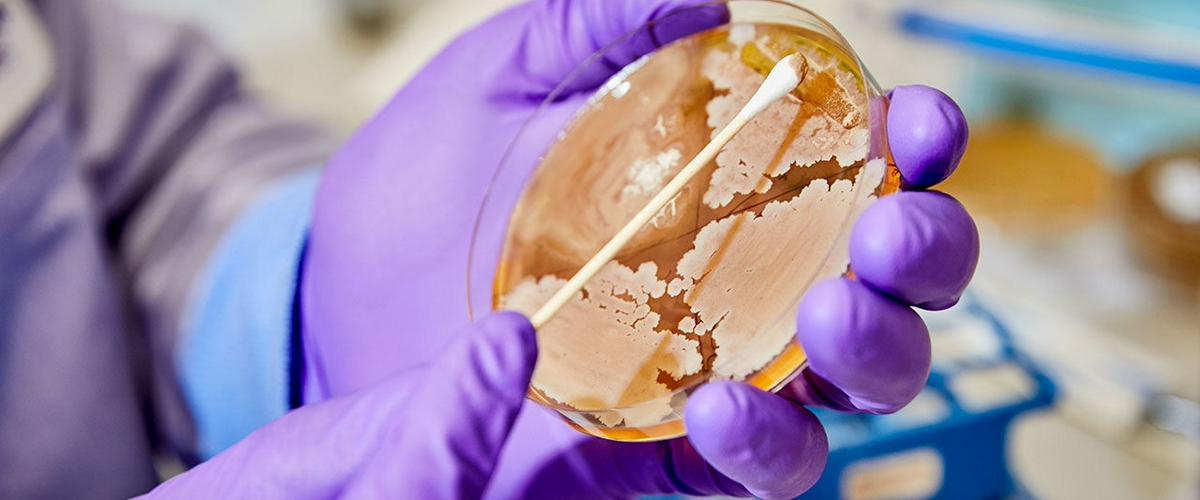
TODO:

В последние годы появляется все больше свидетельств того, что симбиотические бактерии кишечника влияют на работу мозга. Например, у многих пациентов с аутизмом и болезнью Паркинсона наблюдаются расстройства пищеварения, а прием ими антибиотиков усиливает симптомы депрессии. Механизмы, с помощью которых бактерии воздействуют на мозг, могут быть различными: от выделения определенных молекул и стимуляции блуждающего нерва до регуляции воспалительных процессов.
Ученые только начинают понимать роль симбиотических микроорганизмов в работе психики, однако среди биотехнологических стартапов идея о связи кишечника и мозга уже породила настоящую золотую лихорадку. Компании соревнуются за возможность первыми вывести на рынок «психобиотики» — средства для лечения психических расстройств с помощью бактерий. Они должны заменить устаревшие и неэффективные лекарства.
Яркий представитель этого растущего сектора — основанный пять лет назад стартап Holobiome, о котором рассказывает Science Magazine. Его сотрудники планируют разработать «психобиотики» для лечения депрессии, бессонницы, синдрома раздраженного кишечника и болей в области живота и таза.
Они уже достигли значительных успехов в культивации симбиотических бактерий, многие из которых долго сопротивлялись выращиванию в лаборатории. В общей сложности в Holobiome уже культивирует 70% известных науке кишечных бактерий человека.
В ходе экспериментов команда выяснила, что для размножения многих кишечных бактерий необходима гамма-аминомасляная кислота (ГАМК). Это соединение играет важную роль в работе нервной системы, а его неправильная регуляция связана с депрессией и другими психическими расстройствами. Если одни бактерии нуждаются в ГАМК для роста, то, скорее всего, его производят какие-то другие виды бактерий. Исследования позволили выявить три группы симбиотических микроорганизмов, выделяющих эту молекулу, включая виды из рода Bacteroides.
Исследование пациентов с диагнозом депрессия продемонстрировало, что дефицит бактерий Bacteroides в кишечнике связан с гиперактивностью в префронтальной коре, которая может быть причиной этого психического расстройства. А эксперименты с крысами продемонстрировали, что если в кишечнике увеличивается численность ГАМК-продуцирующих бактерий, то растет и концентрация этой молекулы в мозге. ГАМК слишком велика, чтобы преодолеть гематоэнцефалический барьер, так что, скорее всего, она достигает мозга через блуждающий нерв.
Holobiome уже подала патент на препараты против депрессии, основанные на ГАМК-продуцирующих бактериях.
Впрочем, полноценного препарата в распоряжении компании пока нет. В настоящее время ее сотрудники изучают, какие из 30 бактерий-кандидатов лучше всего подойдут для производства «психобиотиков». Возможно, это будет не один вид, а целый комплекс.
Если исследования пойдут по плану, то уже к началу 2021 года стартуют испытания подобных лекарств на людях.
Представители академической науки относятся к производству «психобиотиков» с большой осторожностью. Многим из них ситуация напоминает мыльный пузырь: венчурные фонды с удовольствием финансируют любой стартап, который заявляет своей целью лечение с помощью бактерий. При этом научная основа такой терапии только закладывается. Тем не менее, в Holobiome уверены, что однажды выращиваемые ими бактерии смогут помочь миллионам людей, страдающих от депрессии и других психических расстройств.
Симбиотические бактерии могут регулировать и работу памяти. Как показали эксперименты с мышами, микроорганизмы выделяют молочную кислоту, которая влияет на процесс записи и хранения воспоминаний.